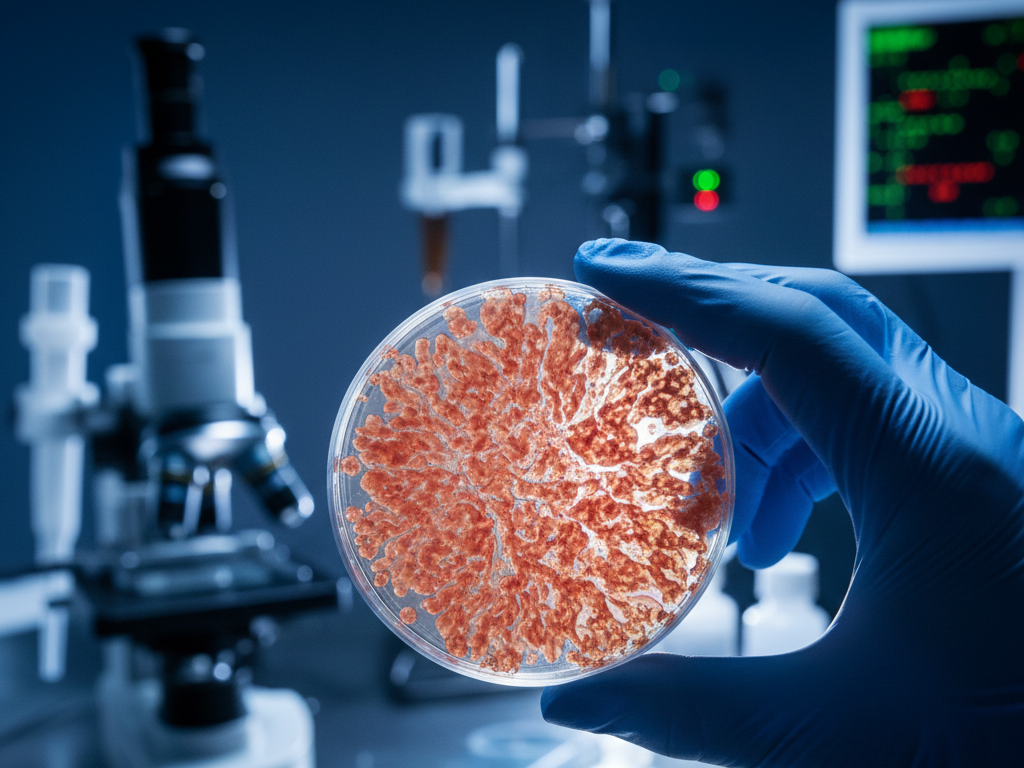

Гастрономическая «русская рулетка»
Главный враг давно известен, но его продолжают покупать килограммами. Переработанное мясо — сосиски, ветчина, бекон, сервилат — это не просто еда, а химический концентрат. Всемирные исследования подтверждают жесткий факт: ежедневное употребление всего 50 граммов такой продукции (это пара ломтиков колбасы) повышает риск рака толстой кишки на 18%.
Проблема кроется не в самом мясе, а в технологии его «бессмертия». Чтобы продукт лежал на полке неделями и сохранял розовый цвет, производители используют нитриты.

Формула мутации
Попадая в желудок, безобидные на вид консерванты вступают в реакцию и превращаются в нитрозамины. Это вещества, которые напрямую атакуют клеточную структуру. ДНК получает повреждения, и механизм естественной защиты дает сбой.
Андрей Нефедов, ведущий научный сотрудник и торакальный хирург ФГБУ «СПб НИИФ», предупреждает: термическая обработка (жарка бекона или сосисок) только усугубляет ситуацию, активируя мутагенные свойства добавок. Единственный безопасный выход — полная замена магазинных полуфабрикатов на домашнее мясо, например, отварную куриную грудку.
Скрытая угроза ультра-еды
Вторая категория риска — ультраобработанные продукты. Это всё, что прошло многоступенчатую промышленную переработку: от чипсов и сладких хлопьев до готовых замороженных обедов. Здесь работает накопительный эффект: увеличение доли такой еды в рационе на 10% дает рост риска онкологии на 4%.
Врач подробно объяснил механизм воздействия на организм:
«С одной стороны, эмульгаторы, консерванты и ароматизаторы могут оказывать прямое токсическое воздействие на клетки, с другой — высокий гликемический индекс таких продуктов провоцирует выброс инсулина и инсулиноподобного фактора роста (IGF-1), которые стимулируют бесконтрольное деление раковых клеток».
Добавьте к этому хроническое воспаление тканей, которое неизбежно при таком питании, и вы получите идеальную среду для зарождения патологии.
Лимит на стейки
С красным мясом (говядина, свинина, баранина) ситуация сложнее. Оно не запрещено, но находится в «желтой зоне». Чрезмерное увлечение стейками провоцирует не только рак толстого кишечника, но и опухоли поджелудочной железы и простаты.
Медицинский стандарт жестко ограничивает порции: максимум 350–500 граммов готового мяса в неделю. Это всего три небольших приема пищи. Всё, что свыше — неоправданный риск.

Миф о безопасном бокале
Если с мясом возможны компромиссы, то с алкоголем врачи категоричны. Этиловый спирт — доказанный канцероген, бьющий по печени, пищеводу, молочным железам и кишечнику. Понятия «безопасная доза» в современной онкологии не существует. Любое количество спиртного повышает вероятность мутаций.
Финальный аккорд в списке угроз — соль. Её избыток (более 5 граммов в сутки) в сочетании с бактерией Helicobacter pylori гарантированно разрушает слизистую желудка. Скрытая соль в хлебе и сыре часто перекрывает суточную норму, даже если вы вообще не пользуетесь солонкой.
Готовы ли вы рискнуть здоровьем ради минутного удовольствия от куска колбасы, зная, что цена может оказаться слишком высокой?
